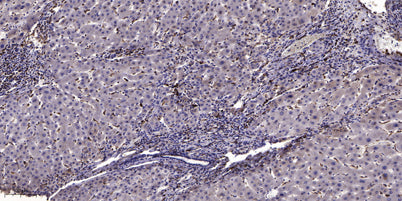
CAC1A rabbit pAb

Product Overview
Product Overview
Applications
IHC;IF
Cellular localization
Cell membrane ; Multi-pass membrane protein .
Clonality
Polyclonal
Concentration
1 mg/ml
Cost per item
74
Geneid human
773
Human swiss prot no
O00555
Immunogen
Synthesized peptide derived from human protein . at AA range: 1401-1450
Isotype
IgG
Observed band
275kD
Product weight
0.005kg
Reactivity
Human;Mouse;Rat
Recommended dilutions
IHC-p 1:50-300
Source
Rabbit
Storage
-20°C/1 year
Documents
Documents
Background
Background
calcium voltage-gated channel subunit alpha1 A(CACNA1A) Homo sapiens Voltage-dependent calcium channels mediate the entry of calcium ions into excitable cells, and are also involved in a variety of calcium-dependent processes, including muscle contraction, hormone or neurotransmitter release, and gene expression. Calcium channels are multisubunit complexes composed of alpha-1, beta, alpha-2/delta, and gamma subunits. The channel activity is directed by the pore-forming alpha-1 subunit, whereas, the others act as auxiliary subunits regulating this activity. The distinctive properties of the calcium channel types are related primarily to the expression of a variety of alpha-1 isoforms, alpha-1A, B, C, D, E, and S. This gene encodes the alpha-1A subunit, which is predominantly expressed in neuronal tissue. Mutations in this gene are associated with 2 neurologic disorders, familial hemiplegic migraine and episodic ataxia 2. This gene also exhibits
Product Citations
Product Citations
More Info
More Info
CAC1A rabbit pAb
CAC1A rabbit pAb
Vendor: ELK Biotechnology
SKU: ES11416
Regular price
$148.00
Sale price
$148.00
Regular price
Unit price
/per
Shipping calculated at checkout.
Documents
Available in stock (100)
×
Request a Quote
- Worldwide delivery & full concierge support
- AI Agent for guided support and curated product search
- Track Your Order Status Anytime
Couldn't load pickup availability
Limited time offer
Get $200 off when you spend $2,500 or more!
Product Overview
Product Overview
Applications
IHC;IF
Cellular localization
Cell membrane ; Multi-pass membrane protein .
Clonality
Polyclonal
Concentration
1 mg/ml
Cost per item
74
Geneid human
773
Human swiss prot no
O00555
Immunogen
Synthesized peptide derived from human protein . at AA range: 1401-1450
Isotype
IgG
Observed band
275kD
Product weight
0.005kg
Reactivity
Human;Mouse;Rat
Recommended dilutions
IHC-p 1:50-300
Source
Rabbit
Storage
-20°C/1 year
Documents
Documents
Background
Background
calcium voltage-gated channel subunit alpha1 A(CACNA1A) Homo sapiens Voltage-dependent calcium channels mediate the entry of calcium ions into excitable cells, and are also involved in a variety of calcium-dependent processes, including muscle contraction, hormone or neurotransmitter release, and gene expression. Calcium channels are multisubunit complexes composed of alpha-1, beta, alpha-2/delta, and gamma subunits. The channel activity is directed by the pore-forming alpha-1 subunit, whereas, the others act as auxiliary subunits regulating this activity. The distinctive properties of the calcium channel types are related primarily to the expression of a variety of alpha-1 isoforms, alpha-1A, B, C, D, E, and S. This gene encodes the alpha-1A subunit, which is predominantly expressed in neuronal tissue. Mutations in this gene are associated with 2 neurologic disorders, familial hemiplegic migraine and episodic ataxia 2. This gene also exhibits
Product Citations
Product Citations
More Info
More Info

CAC1A rabbit pAb
Regular price
$148.00
Sale price
$148.00
Regular price
Unit price
/per